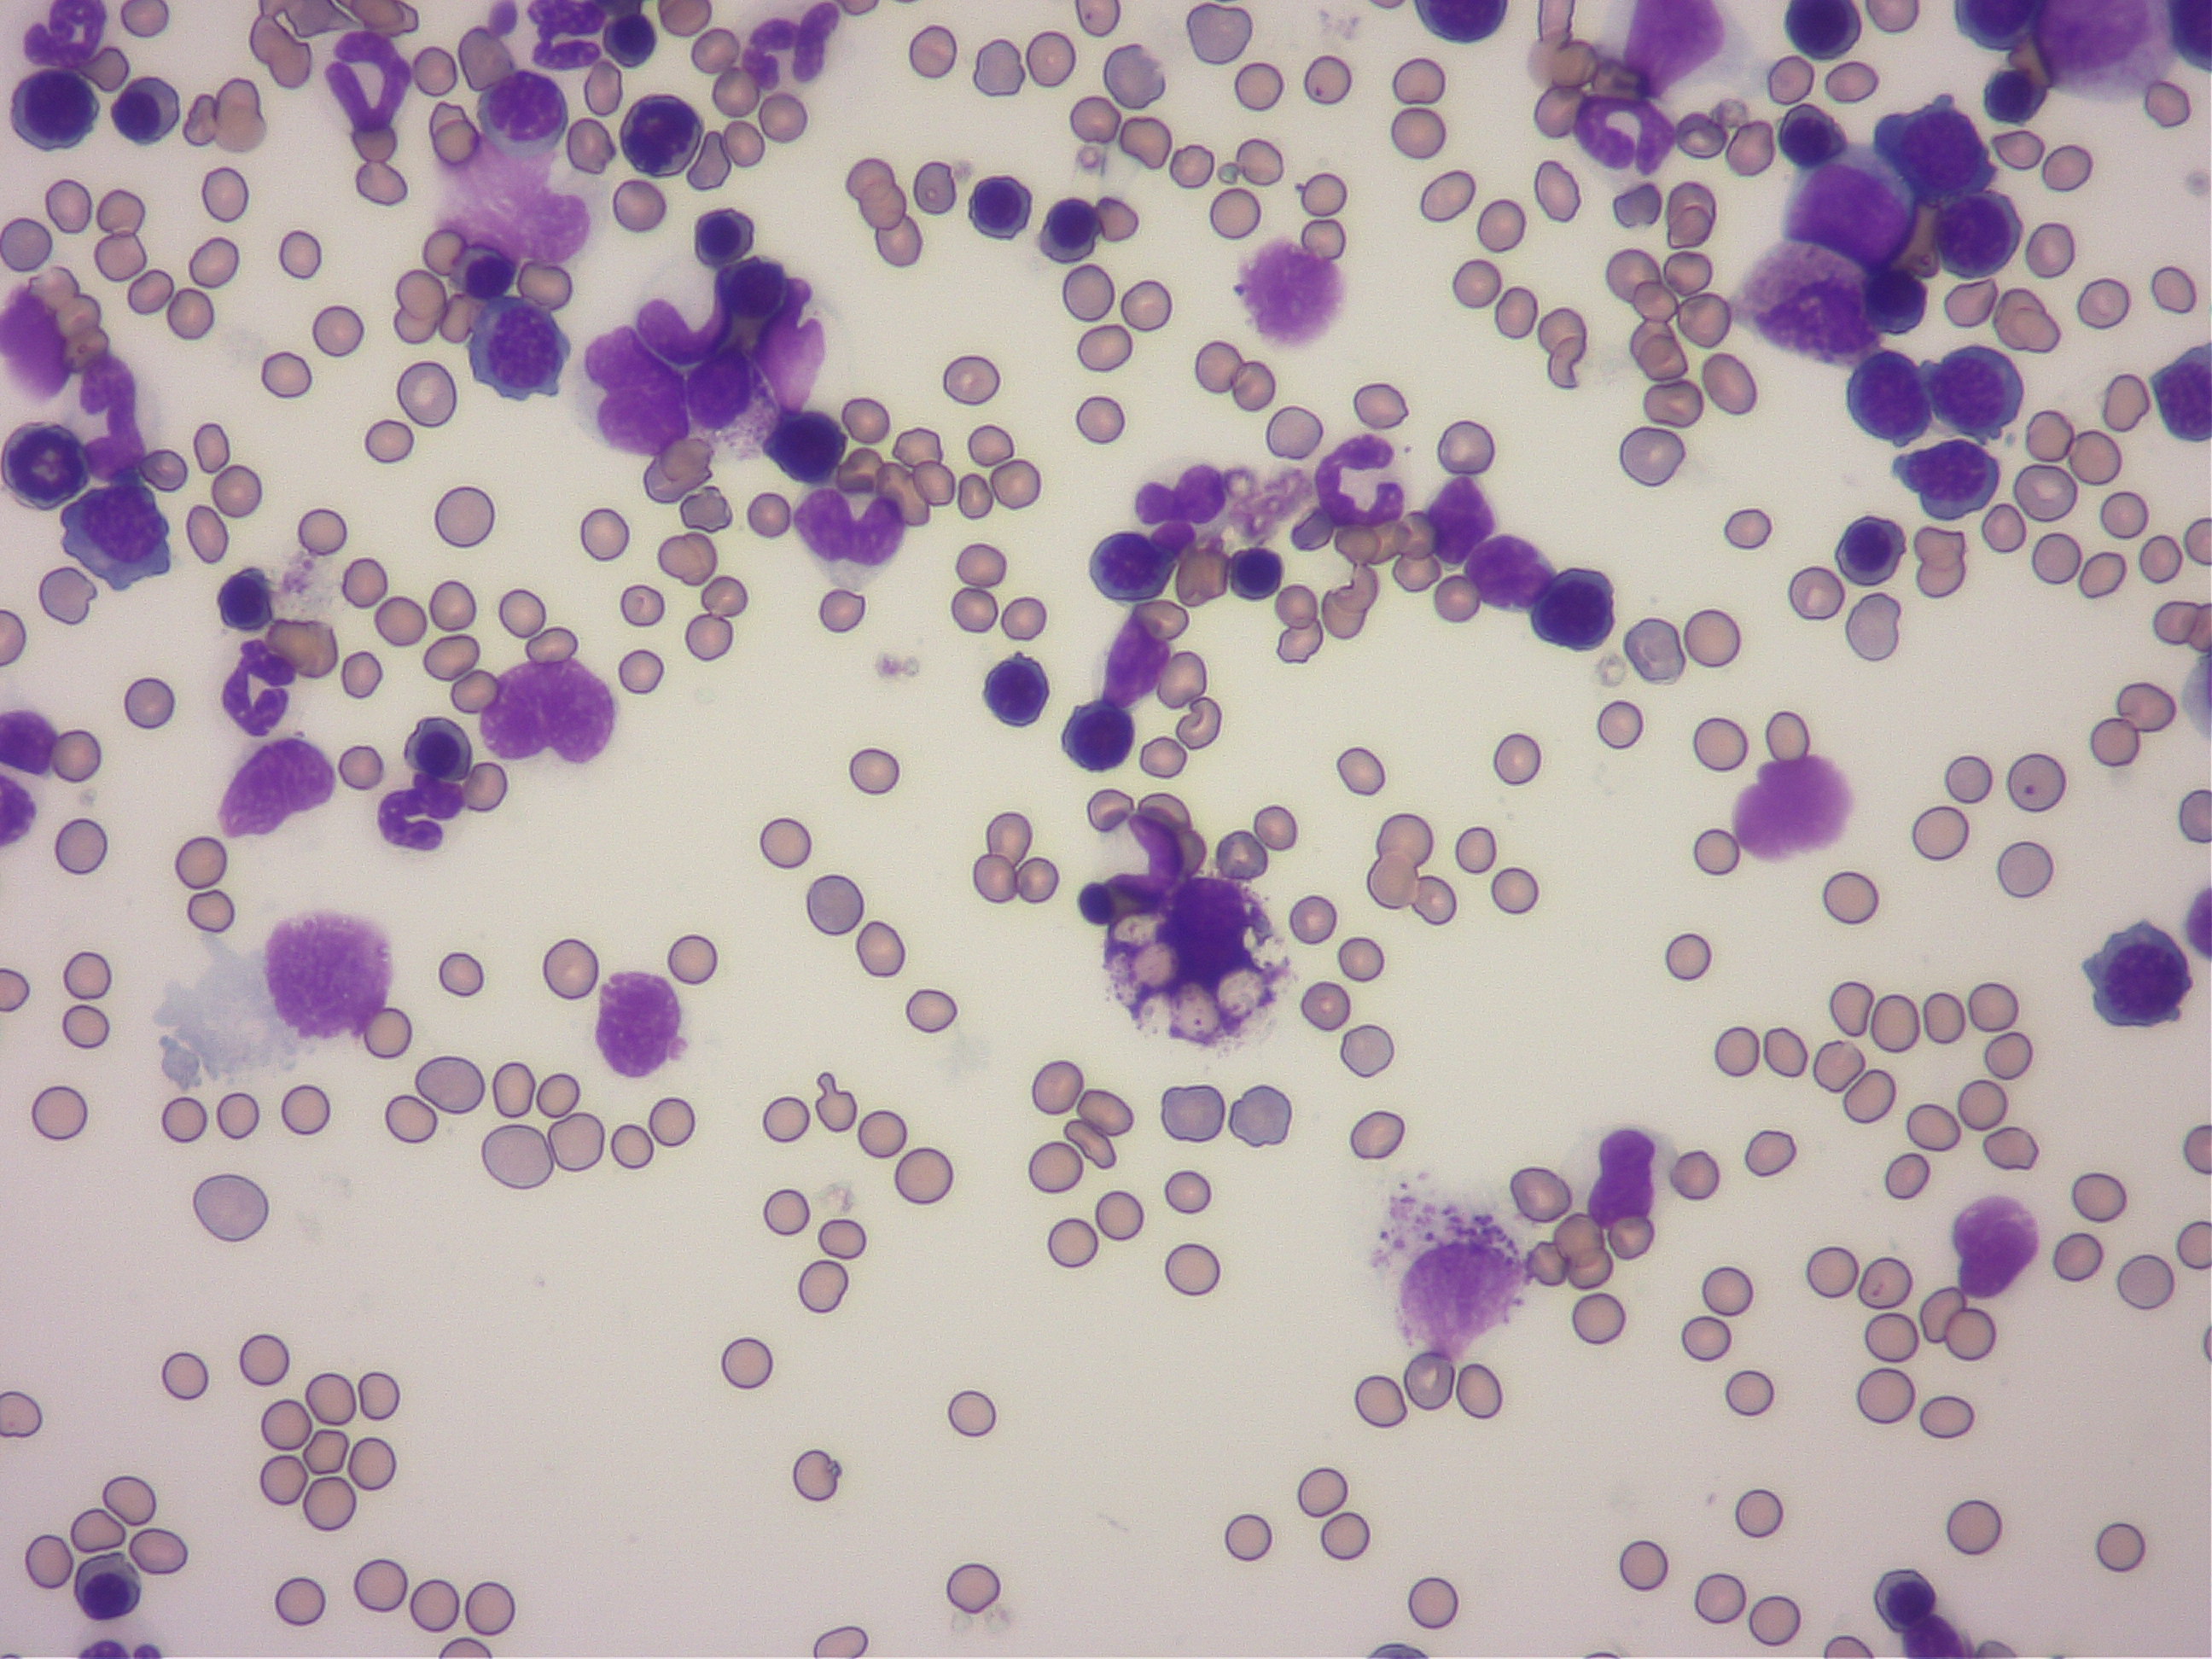
骨髄検査で骨髄内に浸潤した肥満細胞が赤血球を貪食している像
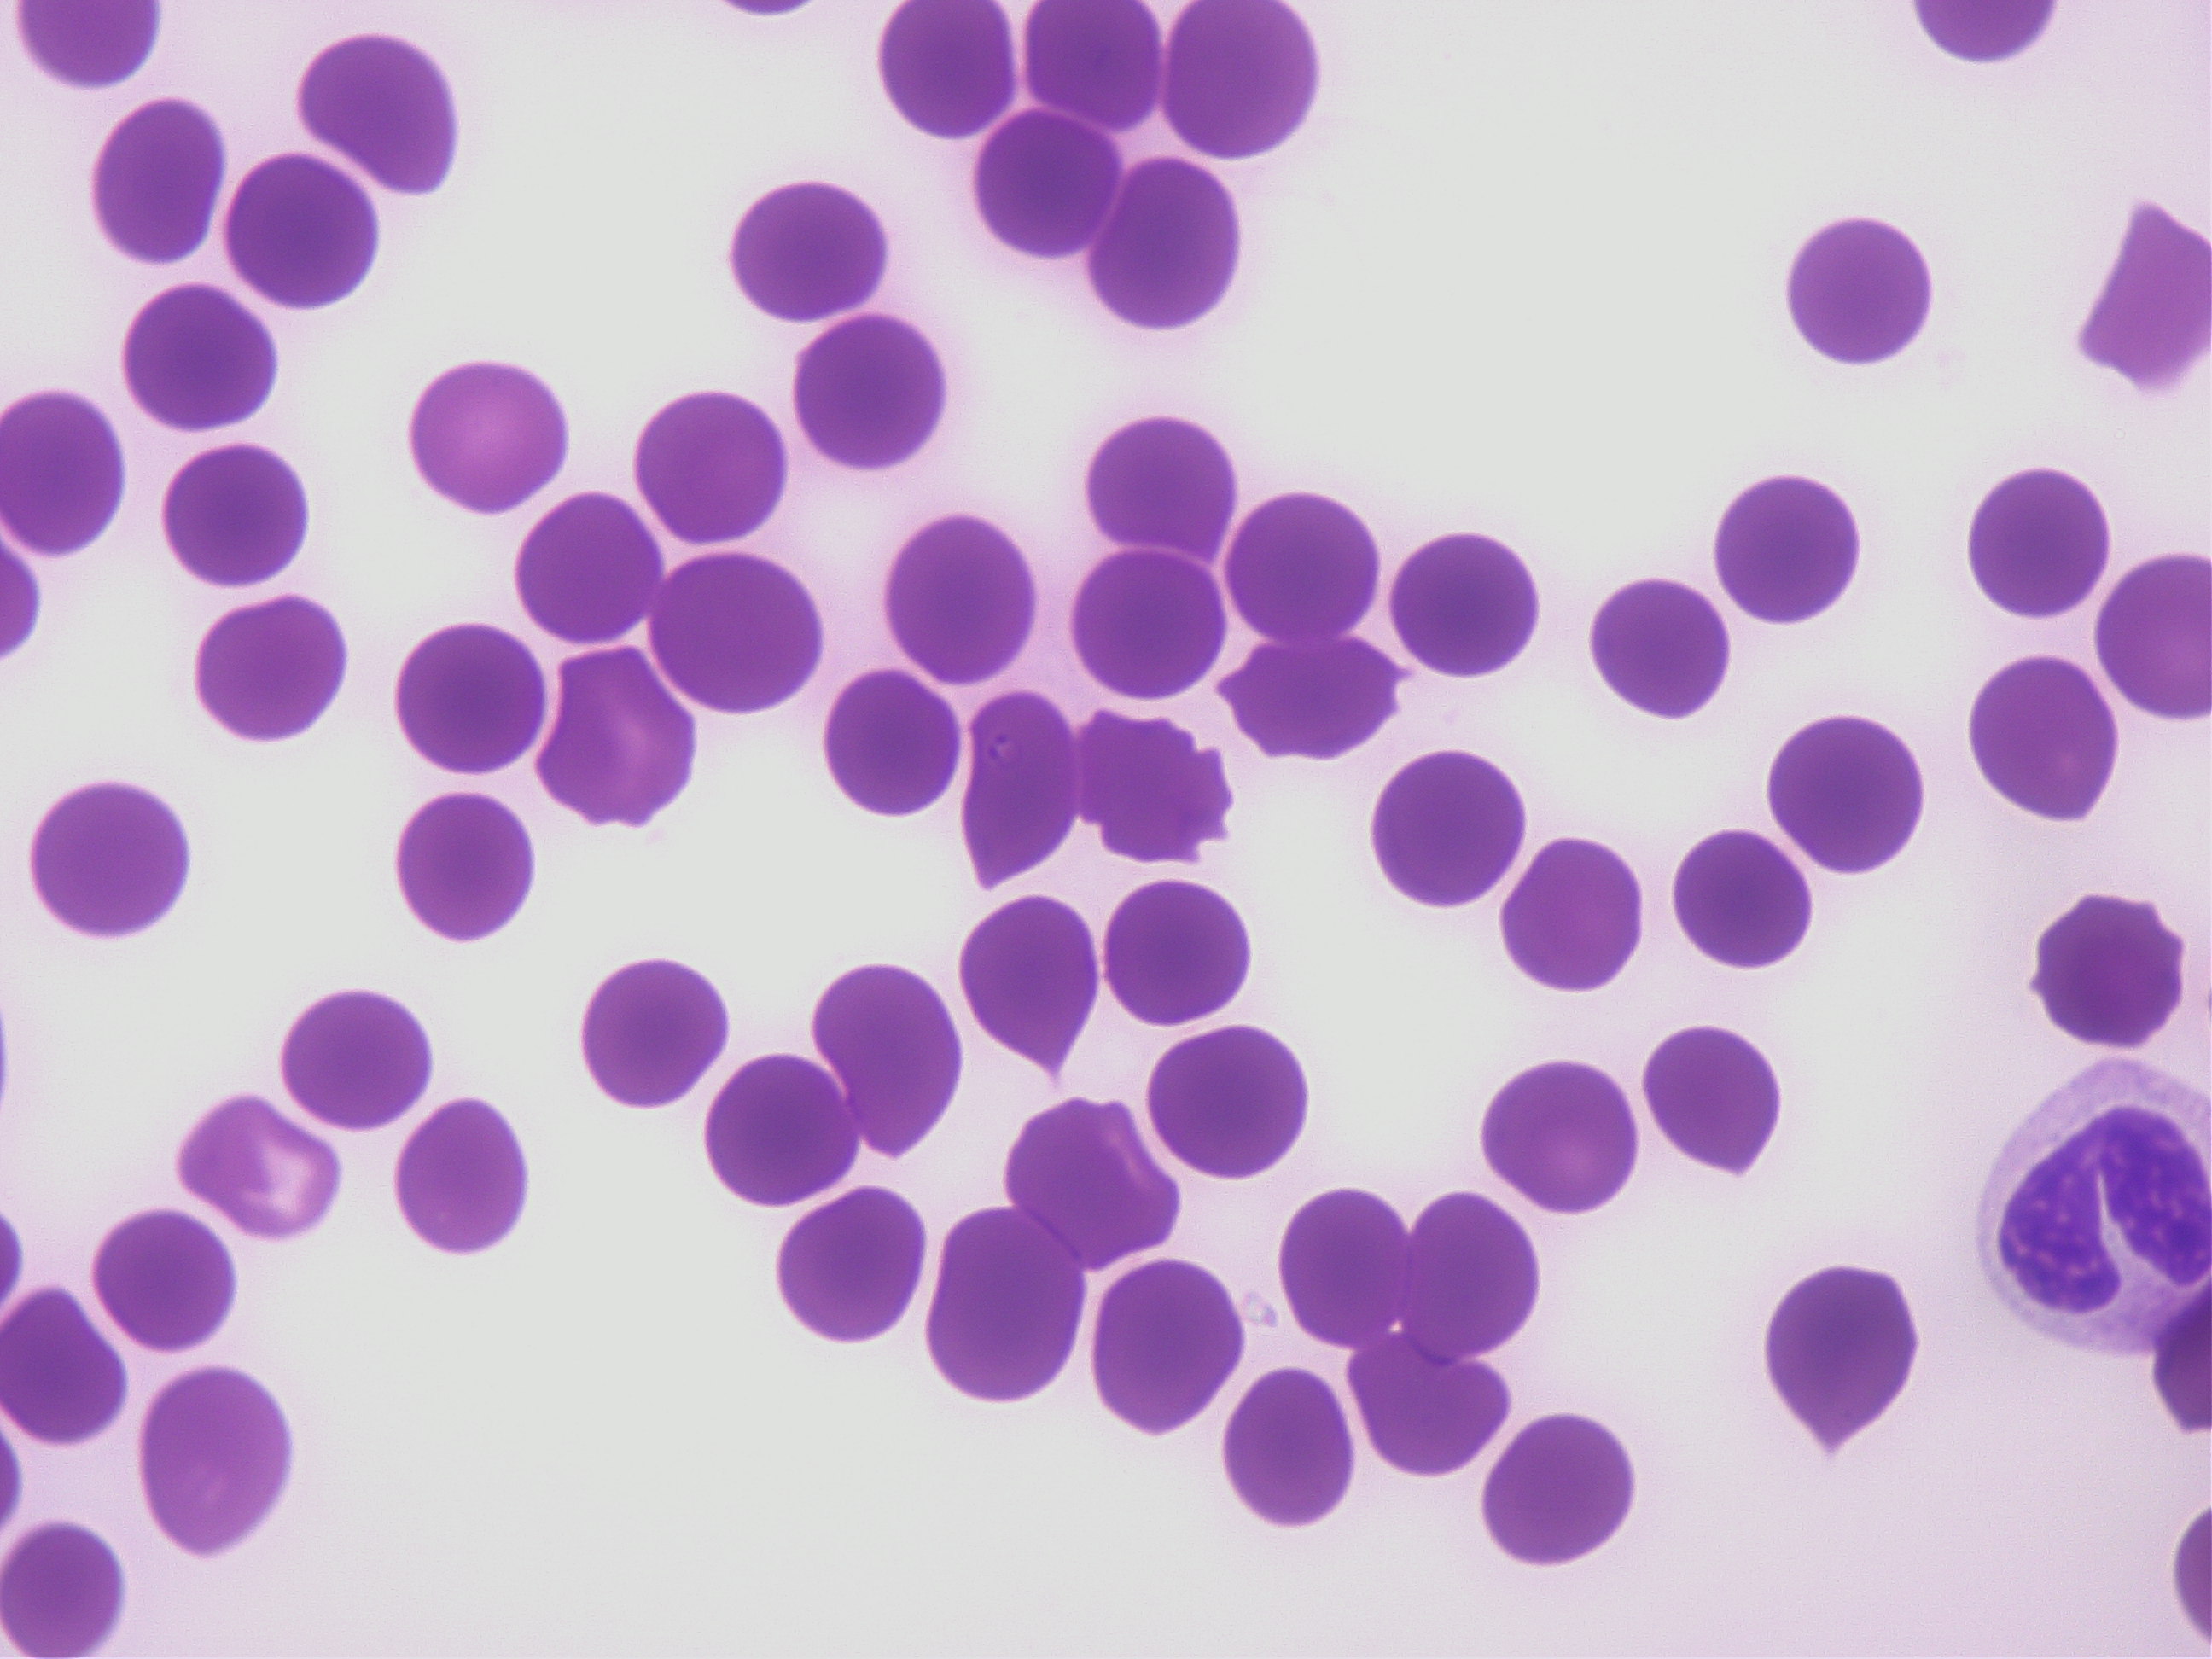
バベシアの虫体がいる血液塗沫検査の画像

みなさん、こんにちは。院長の諏訪です。
ひまわりって素敵ですね!
太陽の方を向いている姿が、志を高くもち、
常に成長しようとする姿に重なって見えます。
僕も負けずにがんばります。
さて本日は貧血の話を少しさせていただきたいと思います。
貧血とは??
貧血とは血液中の赤血球数やヘモグロビン濃度が
正常値より下がった状態をいいます。
貧血が進行していくと当然生きていけなくなります。
なぜ貧血が起こるのか?

赤血球は通常、骨髄の中で作られます。
作られた赤血球は体内に酸素を運んでくれる働きをします。
赤血球は寿命があり、犬では約3ヶ月、猫では約2.5ヶ月ほどになります。
古くなった赤血球は破壊され、その分、新しい赤血球が作られます。
こうしてうまく体の中でバランスをとっているのです。
このバランスが崩れてしまった時、貧血が起こります。
つまり、
1.赤血球は作られているが、寿命がとても短くなっているので
赤血球の産生が追いつかない場合(溶血性貧血など)
2.赤血球がどんどん外に出ていく場合(出血など)
3.赤血球が作られないもしくは産生が低下している場合
です。
再生性貧血と非再生性貧血
貧血の原因はさきほど書いたようになりますが、
貧血にはおおきく再生性貧血と非再生性貧血があります。
上の1-2は再生性、3は非再生性貧血になります。
再生性貧血とは、その字の通り、
赤血球が作られているものの、貧血が起こっている状態です。
非再生性貧血は赤血球が作られていない、
もしくは産生が低下している状態です。

再生性貧血
再生性貧血は通常その原因として、出血と溶血が考えられます。
出血は目に見えてわかるものもあれば、肺出血など診断が難しいものもあります。
溶血性貧血には先天性、免疫介在性、血管障害性(DICなど)、感染性(バベシアなど)、
さらには玉ねぎ中毒などにみられるハインツ小体性など様々な原因があります。
通常、溶血性貧血の原因は稟告や血液塗抹所見、遺伝子検査などを用いて
総合的に判断する必要があります。
それぞれの治療法が異なるため、慎重に診断する必要があります。

非再生性貧血
非再生貧血はその原因として赤血球の産生障害が考えられます。
通常、低形成、ヘモグロビン合成障害、核の成熟障害などが挙げられます。
赤血球の産生工場である骨髄内で問題が起きていることが多いです。
そのため非再生性貧血の鑑別には骨髄検査が必要となる場合があります。
なぜ骨髄検査が必要なのか?
骨髄検査は非再生性貧血の原因を調べる目的で行われます。
白血病や、癌の浸潤、免疫介在性の疾患など、
骨髄検査をすることでその原因を見極め、
治療方針を立てることができます。
もちろんその時の状況によって、
骨髄検査を実施できないこともありますが、
原因が何かわからない状態で治療することは
とても大変ですし、不安です。
本当は癌が原因で抗がん剤治療をしなくてはならないのに、
増血剤などの治療をしてしまう・・
そのようなことがないようにするためにも
骨髄検査は麻酔や鎮静が必要ですが、大切な検査です。
写真は骨髄内に浸潤した肥満細胞が赤血球を貪食している像です。
写真は骨髄内に浸潤した肥満細胞が赤血球を貪食している像です。
貧血がありますが、その原因は癌が関与していることが疑われました。
この子は癌に対する治療を行ったことで貧血の改善がみられました。
貧血の治療
貧血の治療はその原因により様々です。
そのため正確な診断が必要不可欠となります。
例えば上の写真は先日貧血でご紹介いただいた犬の血液塗抹写真ですが、
例えば上の写真は先日貧血でご紹介いただいた犬の血液塗抹写真ですが、
バベシアの虫体が観察されます。
このような場合、ステロイドなどの免疫抑制治療を行うと、
症状がより悪化してしまう場合があります。
駆虫薬を投与して現在は貧血も改善しています。
いかがだったでしょうか?
少し貧血についてお分かりいただけたでしょうか?
貧血の原因はとても多く、時に診断が困難な場合もあります。
ご不明な点がございましたら、お気軽にお尋ねください。
日進月歩の獣医療です。
日々、精進していきます!








